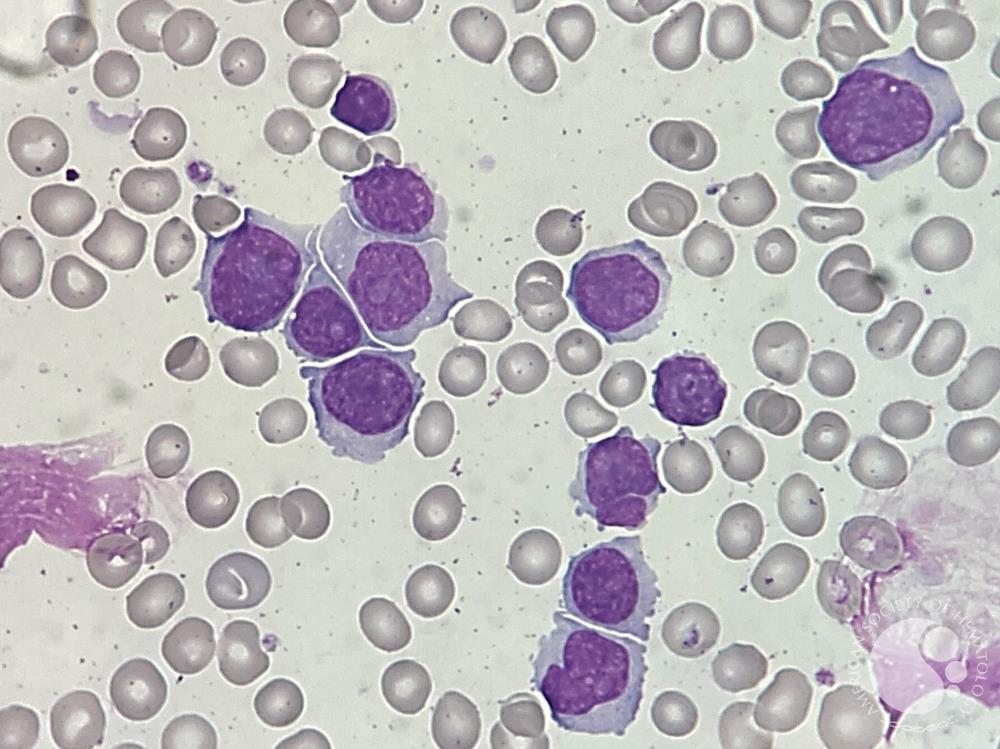

In mantle cell lymphoma (MCL), an aggressive form of B-cell non-Hodgkin lymphoma, TP53 mutations are known to affect patients’ prognosis—but questions remain. What does the heterogeneity of TP53 mutations in MCL look like? And, how does the variation in mutations affect outcomes?
To learn more, TP53 sequencing data from 215 patients at Peking University were collected between 2017 and 2022, with analyses performed that showed several patterns. Results, published this week in Annals of Hematology,1 showed several key patterns.
Mantle Cell Lymphoma | Image: Perla Vicari, MD, PhD, ASH Image Bank
Investigators identified missense mutations as the predominant type, comprising 75.6% of all TP53 mutations detected. The most common base pair change was G:C>A:T (48.31%), with mutations concentrated heavily within the DNA-binding domain (D vgyBD), accounting for 92.41% of cases. Exons 5-8 contained 82.05% of mutations, with the highest frequencies in exon 7 (25.64%) and exon 5 (25.13%). Highly prevalent hotspot mutations were seen on R248, R273, R175, and G245.
TP53 mutations correlated strongly with aggressive disease features. Patients with TP53 mutations showed significantly higher Ki67 proliferation indices (86% had ≥30% vs 64% in wild-type), elevated combined MCL International Prognostic Index (MIPI-c) scores, and increased prevalence of blastoid/pleomorphic subtypes (32% vs 15%). These patients also required more treatment lines, with a higher proportion receiving at least 2 lines of therapy compared to TP53 wild-type patients.
“Stratified by TP53 mutation status, the analysis of clinical characteristics showed a relatively balanced distribution in terms of sex,” the authors wrote, as well as Ann Arbor stage, which describes progression of lymphoma; ECOG status, and lactate dehydrogenase (LDH) level.
The study demonstrated that TP53 mutations significantly worsened both overall survival (OS) and progression-free survival (PFS). Patients with TP53 mutations saw 1-, 3-, and 5-year OS rates of 86.7%, 77.4%, and 58.7%, respectively; the PFS rates were 75%, 33.4%, and 22.3%, respectively. For those without TP53 mutations, the 1- and 3-year OS rates were 97.3% and 85.7%, respectively, while the 5-year OS rate was not achieved. The PFS rates were 88%, 64.7%, and 27.7%, respectively.
The prognostic impact varied substantially based on mutation location. DBD mutations had the strongest adverse effect on survival, while non-DBD mutations showed minimal prognostic significance. Truncating mutations also significantly impaired both OS and PFS.
“No significant differences were observed in the distribution of first-line treatment regimens,” the authors wrote, “or the proportion of patients undergoing [autologous stem cell transplant],” between TP53-mutated and TP53-wild type patients. However more TP53-wild type patients received 2 lines of therapy or less than TP53-mutated patients.
Based on multivariate analysis adjusted for MIPI-c, the researchers established 3 distinct risk categories. The low-risk group included patients without TP53 mutations or with non-DBD mutations. Patients with DBD mutations were in the intermediate-risk group (HR for OS = 3.06). The high-risk group included patients with G245 or R273 mutations (HR for OS = 7.95), with much worse outcomes.
Study authors validated their findings with assays and found that G245 and R273 mutations exhibited markedly reduced transactivation activity and impaired cell growth inhibition. Both mutations reside at the DNA-binding interface of TP53, explaining their profound functional impairments. Unsupervised clustering of functional data—including transactivation activity, cell growth inhibition, structural accessibility, and temperature sensitivity—closely matched the clinical risk stratification.
“The strong concordance between the functional clustering results and our risk model provides further validation for its biological relevance,” the authors wrote.
Although TP53 mutations generally indicate poor prognosis in MCL, they wrote, location-specific analysis reveals heterogeneous impacts, with G245 and R273 mutations representing particularly high-risk genomic events requiring aggressive therapeutic approaches.
The study authors say their work advances MCL management by demonstrating that not all TP53 mutations carry equal prognostic weight. The classification system, they write, offers the ability to dig deeper into the effects of mutations on outcomes beyond their mere presence or absence, with more potential to guide treatment decisions.
Reference
Liu S, Zhou S, Zhang W, et al. TP53 mutation heterogeneity reveals distinct prognoses in mantle cell lymphoma. Ann Hematol (2026);105:44. doi:10.1007/s00277-026-06771-1